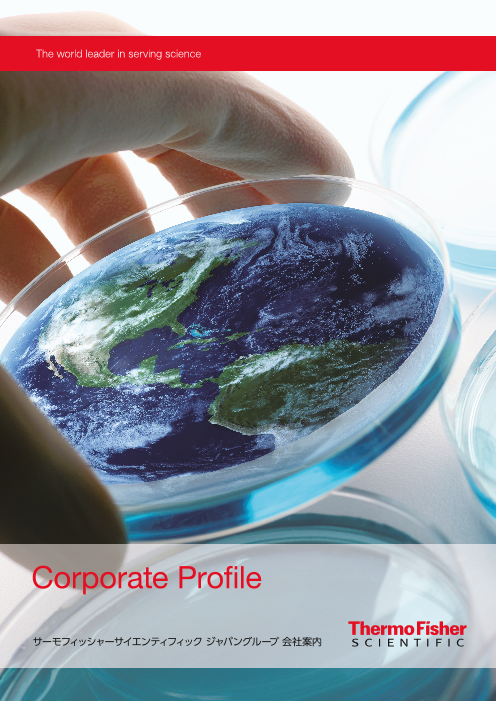
カタログの表紙

サーモフィッシャーダイアグノスティックス株式会社
サーモフィッシャーダイアグノスティックス株式会社
Thermo Fisher Scientific Inc. (NYSE: TMO)は、科学に貢献する世界的リーダーです。
サーモフィッシャーサイエンティフィック インコーポレイテッドについて
米国マサチューセッツ州ウォルサムに本社を置き、世界中に70,000人の従業員を擁しています。総売上高は200億 ドル、研究開発費は約9億ドルに及び、Thermo Scientific、Applied Biosystems、Invitrogen、Fisher Scientific、 Unity Lab Servicesブランドは、世界のさまざまな分野の基礎・応用研究、製品開発、品質管理・保証、安全保障 から医療、製薬・バイオ医薬に至るお客様に広く浸透しています。
企業概要
| 会社名 | サーモフィッシャーダイアグノスティックス株式会社 (さーもふぃっしゃーだいあぐのすてぃっくすかぶしきがいしゃ)
|
|---|---|
| 所在地 |
〒 108-0023 東京都港区4-2-8 住友不動産三田ツインビル東館 |
| 設立 | 2015年11月1日 |
| 事業内容 | アレルギーおよび自己免疫診断ソリューションの輸入販売など |
| FAX | 03-5826-1692 |
| WEBサイト | http://www.phadia.com/ja/ |
| 業種 | その他の化学工業 |